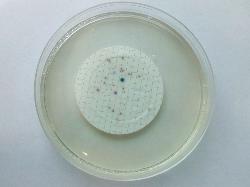

| Water analysis by membrane filtration on CCA. Legend: blue colonies - E. coli; red colonies - coliforms; colorless colonies: possible Pseudomonas aeruginosa. |
PRINCIPLE
Members of the Enterobacteriaceae that express beta-D-galactosidase and beta-D-
glucuronidase (Escherichia coli) produce viole-blue colonies.
Members of the Enterobacteriaceae that express only beta-D-galactosidase (coliforms)
produce rose-red colonies.
PROCEDURE
Water: use the membrane filtration technique. Add the membrane on medium surface and incubate at 36 ºC ± 2 ºC for 24 hours. After
incubation, all blue-violet colonies are E. coli. All red to rose colonies are presumptive coliforms. Presumptive coliform colonies are
confirmed by oxidase test (oxidase-negative).
Besides the water and food applications, the medium may be used by direct plating for
other purposes.
NOTE
Some strains of E. coli which are beta-D-glucuronidase negative, such as Escherichia
coli O157, will not be detected as E. coli. As they are beta-D-galactosidase positive,
they will appear as coliform bacteria on this chromogenic agar.
QUALITY CONTROL
Escherichia coli ATCC 25922: violet colonies, 2 - 4 mm in diameter;
Enterobacter aerogenes ATCC 13048: rose to red colonies, 1 - 2 mm in dimater;
Enterococcus faecalis ATCC 29212: no growth, complete inhibition;
Pseudomonas aeruginosa ATCC 27853 : good growth, colourless colonies.
REFERENCES
1. ISO 9308-1:2014(en) Water quality - Enumeration of Escherichia coli and coliform bacteria - Part 1: Membrane filtration method for
waters with low bacterial background flora.
2. PO5317A. Chromogenic Coliform Agar. Oxoid / Thermo Scientific - product leaflet.
Members of the Enterobacteriaceae that express beta-D-galactosidase and beta-D-
glucuronidase (Escherichia coli) produce viole-blue colonies.
Members of the Enterobacteriaceae that express only beta-D-galactosidase (coliforms)
produce rose-red colonies.
PROCEDURE
Water: use the membrane filtration technique. Add the membrane on medium surface and incubate at 36 ºC ± 2 ºC for 24 hours. After
incubation, all blue-violet colonies are E. coli. All red to rose colonies are presumptive coliforms. Presumptive coliform colonies are
confirmed by oxidase test (oxidase-negative).
Besides the water and food applications, the medium may be used by direct plating for
other purposes.
NOTE
Some strains of E. coli which are beta-D-glucuronidase negative, such as Escherichia
coli O157, will not be detected as E. coli. As they are beta-D-galactosidase positive,
they will appear as coliform bacteria on this chromogenic agar.
QUALITY CONTROL
Escherichia coli ATCC 25922: violet colonies, 2 - 4 mm in diameter;
Enterobacter aerogenes ATCC 13048: rose to red colonies, 1 - 2 mm in dimater;
Enterococcus faecalis ATCC 29212: no growth, complete inhibition;
Pseudomonas aeruginosa ATCC 27853 : good growth, colourless colonies.
REFERENCES
1. ISO 9308-1:2014(en) Water quality - Enumeration of Escherichia coli and coliform bacteria - Part 1: Membrane filtration method for
waters with low bacterial background flora.
2. PO5317A. Chromogenic Coliform Agar. Oxoid / Thermo Scientific - product leaflet.
COMPOSITION
Casein peptone 1.0 g, yeast extract 2.0 g, sodium chloride 5.0 g, sodium hydrogen
phosphate x 2H2O 2.2 g, di-sodium hydrogen phosphate 2.7 g, sodium pyruvate 1.0 g,
sorbitol 1.0 g, tryptophane 1.0 g, tergitol 7 1.15 g, 6-Chloro-3-indoxyl-beta-D-
-galactopyronoside 0.2 g, 5-Bromo-4-chloro-3-indoxyl-beta-D-glucuronic acid 0.1 g,
Isopropyl-ß-D-thiogalactopyranoside (IPTG) 0.1 g, agar 12.5 g.
Distilled water ad 1000 ml, pH 7.2 ± 0.2.
Bring to the boil to dissolve the agar completely. Do not autoclave!
Dispense into Petri dishes.
Casein peptone 1.0 g, yeast extract 2.0 g, sodium chloride 5.0 g, sodium hydrogen
phosphate x 2H2O 2.2 g, di-sodium hydrogen phosphate 2.7 g, sodium pyruvate 1.0 g,
sorbitol 1.0 g, tryptophane 1.0 g, tergitol 7 1.15 g, 6-Chloro-3-indoxyl-beta-D-
-galactopyronoside 0.2 g, 5-Bromo-4-chloro-3-indoxyl-beta-D-glucuronic acid 0.1 g,
Isopropyl-ß-D-thiogalactopyranoside (IPTG) 0.1 g, agar 12.5 g.
Distilled water ad 1000 ml, pH 7.2 ± 0.2.
Bring to the boil to dissolve the agar completely. Do not autoclave!
Dispense into Petri dishes.
DESCRIPTION
The medium is used for for the detection and enumeration of coliforms in foods and water by membrane filtration technique.
The medium is used for for the detection and enumeration of coliforms in foods and water by membrane filtration technique.
| Chromogenic Coliform Agar (CCA) |

(c) Costin Stoica
| Antibiogram |
| Encyclopedia |
| Culture media |
| Biochemical tests |
| Stainings |
| Images |
| Movies |
| Articles |
| Identification |
| Software |
| R E G N U M PROKARYOTAE |
| Back |